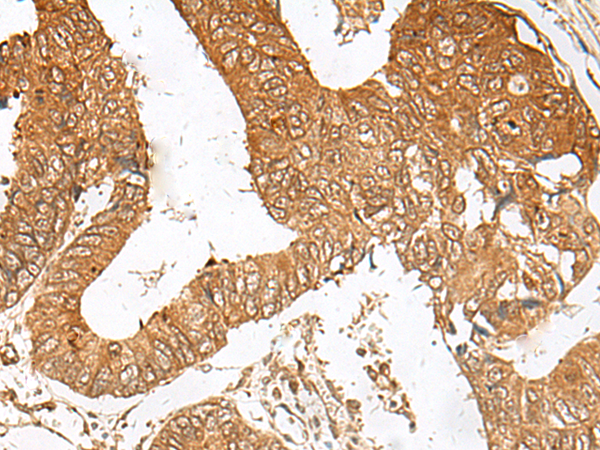
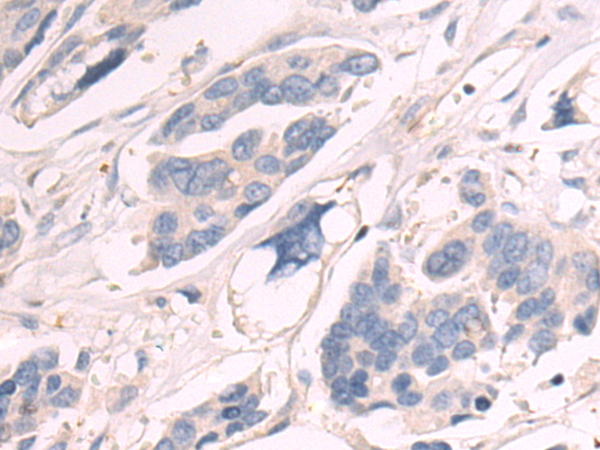

-
分类: 科研抗体货号: P09703别名: L3; ASC-1; TARBP-B应用: WB,IHC反应种属: Human, Mouse, Rat
-
分类: 科研抗体货号: P09704别名: TAPP1应用: IHC反应种属: Human
-
分类: 科研抗体货号: P09720别名: CYB5RP; LLCDL3应用: IHC反应种属: Human, Mouse, Rat
-
分类: 科研抗体货号: P09702别名: SPF45应用: WB,IHC反应种属: Human, Mouse
-
分类: 科研抗体货号: P09719别名: SM15; IFNRP; SKMc15应用: IHC反应种属: Human
-
分类: 科研抗体货号: P09734别名: SEPT10应用: WB,IHC反应种属: Human, Mouse, Rat
-
分类: 科研抗体货号: P09718别名: BOZF1; ZBTB8; ZNF916A应用: WB,IHC反应种属: Human, Mouse, Rat
-
分类: 科研抗体货号: P09733别名:应用: IHC反应种属: Human, Mouse
-
分类: 科研抗体货号: P09717别名: GNTM; C24GNT; C2GNT2; C2GNTM; C2/4GnT应用: IHC反应种属: Human, Rat
-
分类: 科研抗体货号: P09732别名: K-ALPHA-1应用: WB,IHC反应种属: Human, Mouse, Rat

鄂公网安备42018502007531号
鄂公网安备42018502007531号

